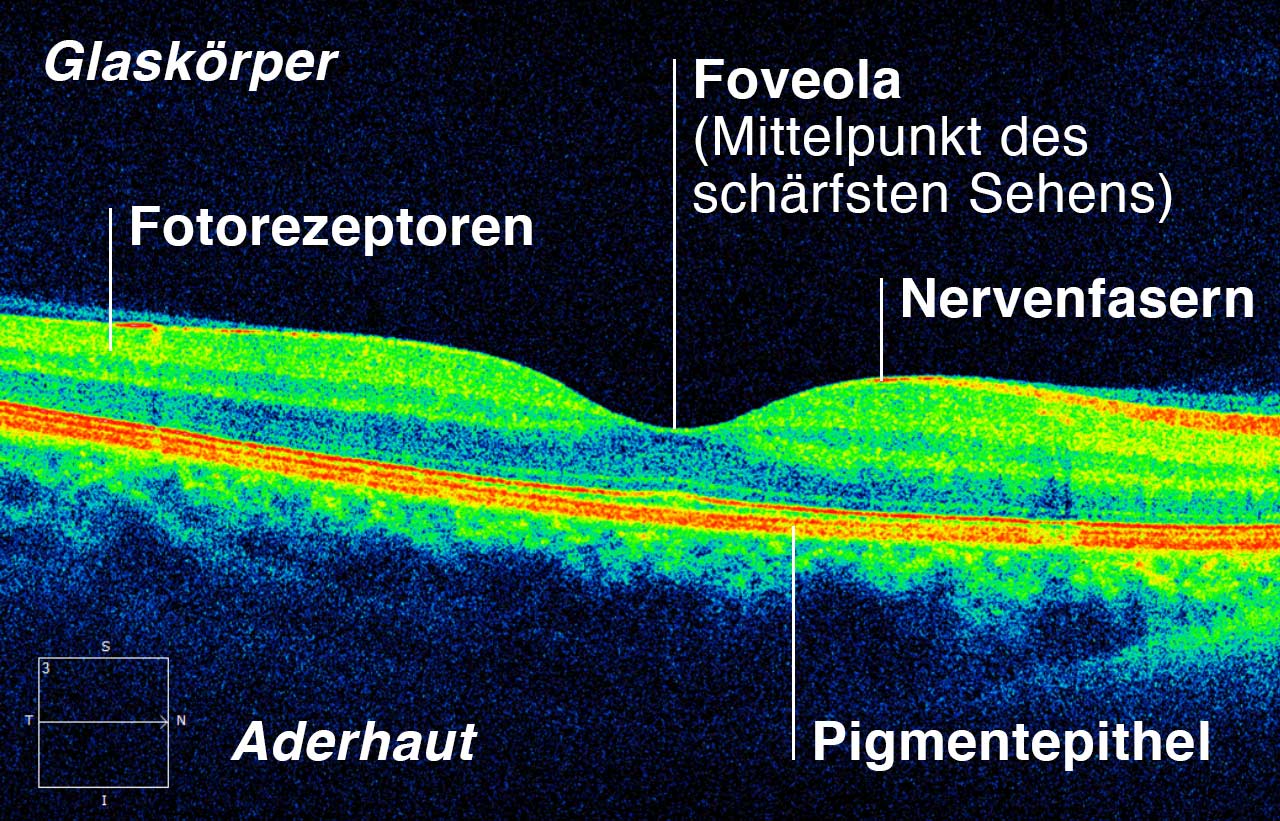

Detaillierte Querschnittsanalyse der Gewebestruktur der Netzhaut
Die optische Kohärenztomographie (OCT) dient der schichtweisen Untersuchung des Augenhintergrundes. So können folgenschwere Netzhauterkrankungen frühzeitig erkannt werden. Dieses Verfahren nimmt eine Querschnittsanalyse der Gewebestruktur der Netzhaut vor und ähnelt damit einer Ultraschall-Untersuchung – nur ist es schneller und liefert eine etwa 40-fach höhere Bildauflösung. So können auch Feinheiten klar differenziert werden.
Dadurch dass die Netzhaut nicht nur oberflächlich, sondern auch in Schichten abgebildet wird, erlangt der Augenarzt tiefere Kenntnisse über die Beschaffenheit der Netzhaut und der Aderhaut. So kann die optische Kohärenztomographie oft auch aufwändige fluoreszenzangiografische Untersuchungen ersetzen, bei denen zunächst Farbstoffe injiziert werden müssen, um eine Abbildung unterschiedlicher Schichten zu ermöglichen.
Je nach Art der OCT-Untersuchung werden die Messwerte automatisch mit Mustern aus statistischen Normgruppen verglichen. Gerade bei einem Glaukom (Grüner Star) lassen sich dessen Anzeichen in der Anfangsphase kaum von normalen, altersbedingten Veränderungen unterscheiden. Im Rahmen einer Computeranalyse kann die Beschaffenheit der Netzhaut mit der von anderen Personen gleichen Alters und gleichen Geschlechts verglichen werden, um Anomalien aufzuzeigen, die nicht auf den ersten Blick ersichtlich sind.
So ist insbesondere die OCT der Makula (zentraler Punkt der Netzhaut, siehe Abbildung) eine der wichtigsten Basisuntersuchungen in der Augenheilkunde geworden.
Die OCT-Untersuchung geht ähnlich schnell und einfach wie die SLO-Untersuchung, bietet dafür aber bei weniger großem Blickwinkel eine tiefergehende Diagnostik mit Fokus auf das Detail. In der Regel ist diese Untersuchung teurer als eine SLO-Untersuchung. Eine Pupillenerweiterung ist im Regelfall nicht notwendig, kann gegebenenfalls aber für aussagekräftigere Untersuchungsergebnisse sorgen.
Hinweis: Vorsorgeuntersuchungen zur Früherkennung von Augenerkrankungen werden generell nicht von gesetzlichen Krankenkassen getragen, sondern gelten als private Investition in die Gesundheit. Der Patient muss die Vorsorge also explizit wünschen und selbst bezahlen.
Beispiel OCT-Scan
Querschnittsanalyse der Netzhautschichten
Folgende Augenkrankheiten sind mit dem OCT frühzeitig feststellbar
- Altersabhängige Makuladegeneration (AMD)
Die AMD beginnt mit der Ablagerung unterhalb der Netzhaut. Dabei kommt es zu einer Dickenzunahme, die sehr genau mit dem OCT gemessen wird. Außerdem kann mit dem OCT festgestellt werden, ob es sich um die feuchte oder trockene Makuladegeneration handelt.
- Diabetische Retinopathie
Bei dieser Erkrankung kommt es neben einer Durchblutungsstörung zu einer Flüssigkeitseinlagerung in der Netzhaut. Die Möglichkeit einer Behandlung richtet sich nach der Ausdehnung dieser Veränderung. Mit dem OCT kann man diese sehr genau messen.
- Glaukom
Hierbei kommt es zu einem langsamen Absterben bestimmter Sehzellen. Dies ist für die Betroffenen erst in einem weit fortgeschrittenen Stadium feststellbar, da die Sehschärfe lange nicht beeinträchtigt ist. Eine Abnahme der Netzhautdicke im Bereich des Sehnervenkopfes und im Bereich der Makula (Gelber Fleck) ist ein frühes Zeichen des Glaukoms. Eine sehr genaue Diagnostik und Verlaufskontrolle ermöglicht das Papillen-OCT mit seiner integrierten Datenbank. Diese vergleicht die Referenzwerte mit den am Patienten gemessenen Werten.
- Makulaforamina, entzündliche Veränderungen
Eine Lochbildung in der Netzhautmitte (Makulaforamen) ist nur mit dem OCTdarstellbar und messbar. Eine möglichst genaue Dokumentation der Ausmaße entzündlicher Veränderungen ist von großer Bedeutung, um frühzeitig eine Größenzunahme festzustellen.
OCT-3D-Ansichten
OCT 3D Darstellung der Netzhautschichten:

OCT 3D Darstellung der Sehgrube:


